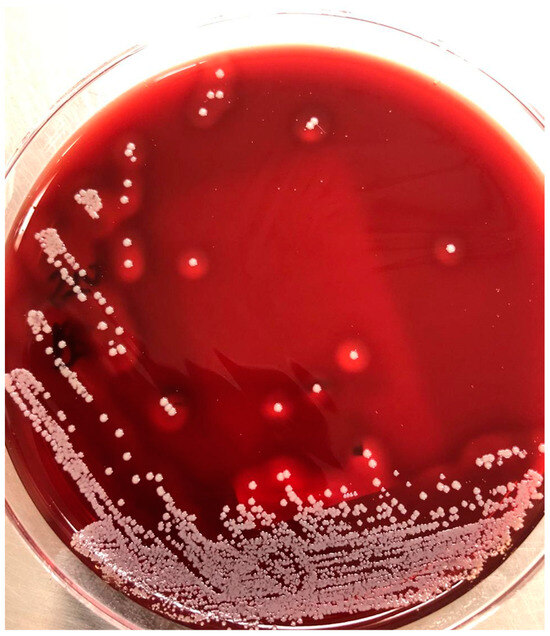

Abstract
Background/Objectives: Infection poses a significant threat of mortality in patients with chronic kidney disease (CKD) undergoing hemodialysis. Staphylococcus aureus (S. aureus) is a common etiological agent, with prior nasal colonization identified as a risk factor for infection. The aim of the present cross-sectional study was to determine the prevalence of nasal S. aureus carriage among patients with CKD undergoing dialysis at a university hospital and identify potential factors associated with colonization. Methods: Nasal swabs were obtained, and bacterial isolates were identified using matrix-assisted laser desorption/ionization time-of-flight spectrometry and antibiogram testing with the Vitek 2 system. Demographic and clinical data were collected for the investigation of risk factors associated with colonization. Results: Among the 96 patients analyzed, 34 were carriers of S. aureus. Among these carriers, three (8.8%) harbored oxacillin-resistant strains. More than half of the S. aureus strains exhibited resistance to clindamycin but susceptibility to oxacillin. Colonization was associated with age and the use of corticosteroids/immunosuppressants. Conclusions: The prevalence of nasal S. aureus carriage was high among patients undergoing dialysis at the university hospital, exceeding that found in the general population. Nasal colonization by S. aureus was linked to corticosteroid use and age. Understanding factors associated with S. aureus nasal colonization in patients on dialysis can assist healthcare providers in preventing the spread of infection and cross-contamination, while reducing risk in this population.
1. Introduction
Patients undergoing hemodialysis are predisposed to healthcare-associated infections, which are associated with high morbidity and mortality rates [1,2,3]. This susceptibility arises from the dialysis procedure itself as well as the deficient innate and adaptive immunity found in this population [4,5,6]. Moreover, bacterial virulence and adherence properties are crucial to the pathogenesis of infection in these patients [7]. Staphylococcus aureus (S. aureus) is the most prevalent etiological agent in vascular access-related infections among patients on dialysis, with a mortality rate of around 25% [8,9,10].
Nasal colonization by S. aureus is a recognized risk factor for the development of infections caused by this microorganism [11,12,13,14,15] and is also a potential source of bacterial dissemination in the environment, promoting person-to-person transmission through direct or indirect contact [11,12,15]. The risk of bloodstream infection among patients with CKD undergoing dialysis who are nasal carriers of methicillin-sensitive S. aureus (MSSA) is four times higher compared to non-carriers [8,16]. Phage typing, which is a laboratory method used to characterize the susceptibility of different strains of microorganisms to specific bacteriophages, and plasmid DNA analysis have demonstrated that 80–90% of S. aureus infections in such patients originate endogenously, meaning that the causative agent of infection is already colonizing the individual [8,11,12,15]. Although we are exposed to S. aureus on a daily basis, only a few individuals are long-term carriers [17]. Longitudinal studies distinguish distinct patterns of nasal S. aureus carriage in healthy individuals: persistent (10–35%), intermittent (20–75%), and non-carrier (5–50%) [6,17,18,19].
The prevalence and incidence of nasal S. aureus carriage vary depending on the population studied [20]. Patients with CKD undergoing hemodialysis often have multiple risk factors for bacterial colonization, such as diabetes, advanced age, repeated exposure to healthcare procedures, prolonged hemodialysis, use of dialysis catheters, and frequent exposure to antibiotics [14,21,22]. Consequently, the prevalence of nasal S. aureus carriage in such individuals is high, with rates ranging from 27 to 60% in different studies [11,12,14,22].
Nasal colonization by S. aureus is highly prevalent among patients undergoing dialysis and poses a significant risk of infection, particularly bacteremia. Such infections are associated with high mortality and morbidity rates. However, there is a lack of studies exploring potential factors linked to this colonization. Therefore, further research on such factors is essential and will assist in identifying patients with a greater likelihood of nasal colonization by this pathogen. The present study is a cross-sectional subset of a pilot study comparing treatments for nasal decolonization among patients undergoing dialysis who are carriers of nasal S. aureus [23]. The aim was to determine the prevalence of nasal S. aureus carriage in patients with CKD at a hemodialysis unit of a university hospital and identify potential factors associated with colonization.
2. Materials and Methods
2.1. Materials
- Nasal Swabs: Sterile swab-type collectors (Absorve®, Cralplast, Cotia, SP, Brazil) for nasal sample collection.
- Transport Medium: Tubes containing Stuart medium for transporting swab samples to the laboratory.
- Culture Media: Blood agar plates.
- Mass Spectrometry Matrix: α-Cyano-4-hydroxycinnamic acid (HCCA) for ionization in MALDI-TOF analysis.
- Chemical Reagents for Matrix Preparation: This study used a preprepared matrix. No acid was included in the matrix composition.
- Mass Spectrometry Equipment: MALDI-TOF system (bioMérieux®, Marcy-l’Étoile, France) for bacterial identification.
- Antimicrobial Susceptibility Testing System: Vitek 2 system (bioMérieux®), including AST-P637 cards for Gram-positive cocci.
- Quality Control Strains: Staphylococcus aureus ATCC 29213, Candida glabrata ATCC MYA-2950, Klebsiella aerogenes ATCC 13048, and Escherichia coli ATCC 25922 to validate test accuracy.
- Antibiotics Tested: Tigecycline, clindamycin, vancomycin, erythromycin, teicoplanin, gentamicin, levofloxacin, sulfamethoxazole–trimethoprim, linezolid, rifampicin, penicillin, and oxacillin.
- Densitometer: Used to standardize bacterial suspension turbidity at 0.5–0.63 McFarland units (DensiChek™, bioMérieux®, Marcy-l’Étoile, France) [24,25,26].
2.2. Study Duration and Population
This cross-sectional study received approval from the Institutional Review Board of Nove de Julho University (certificate number: 3505587) and the Institutional Review Board of the hospital affiliated with the School of Medicine of the University of São Paulo (certificate number: 3645881). Individuals undergoing treatment were recruited from the hemodialysis service, and those who agreed to participate signed a statement of informed consent. The authors followed the STROBE checklist for cross-sectional studies. Surveys were conducted during hemodialysis sessions at the hospital from November 2019 to November 2021. Biological samples collected during these sessions were sent to the Central Laboratory Division—Microbiology Section at the hospital. The samples were processed using standard microbiological methods, including cultures. Colonies displaying typical characteristics of S. aureus were transferred to an additional plate for bacterial identification using MALDI-TOF (bioMérieux®).
2.3. Sample Size Calculation
A non-probabilistic convenience sample based on accessibility or availability was used to estimate the prevalence of nasal S. aureus carriage in patients with CKD receiving treatment at the hemodialysis service. In total, 113 patients were initially recruited, 17 of whom declined to participate in this study. Thus, 96 patients were screened for S. aureus.
2.4. Eligibility Criteria
Male and female patients with CKD 18 years of age or older undergoing hemodialysis at the university hospital were included. Patients with active S. aureus infection, those with no nasal disease or obstruction, and those involved in other studies were excluded.
2.5. Questionnaire Addressing Factors Associated with S. aureus Colonization
Clinical and demographic data were collected from all 96 participants to assess potential factors associated with nasal S. aureus carriage in this population. These factors included age, sex, marital status, occupation, education, housing, etiology of CKD, comorbidities, duration of dialysis treatment before initiation of the protocol, presence of smoking, type and duration of venous access, history of kidney transplantation, systemic antibiotic therapy in the previous 12 months, hospitalization, and infection (including skin infection) in the previous 12 months. The steps of Section 2.2, Section 2.3, Section 2.4, Section 2.5 and Section 2.6 are schematically summarized in Figure 1.

Figure 1.
Flowchart illustrating recruitment and data collection process. Among 113 patients recruited based on eligibility criteria at dialysis service, 17 were excluded due to declining participation or involvement in other studies. Ninety-six patients completed the questionnaire and provided nasal secretion samples for microbiological analysis (cultures).
2.6. Isolation of S. aureus in Recruited Patients
For the detection of nasal S. aureus, trained researchers collected samples from patients who met the eligibility criteria using sterile swab-type collectors (Absorve®). For the procedures, two trained researchers equipped with nasal swabs collected samples in different shifts (morning and afternoon) and on different days (Monday to Saturday) of hemodialysis treatment. A standardized technique was employed: five gentle circular movements in each anterior nostril [22]. The same swab was used in both nostrils (Figure 2). The swabs were transported in tubes containing Stuart medium within four hours and sent to the microbiology laboratory.
Figure 2.
Streaking on blood agar plate.
All swabs were streaked on blood agar plates. Colonies typical of S. aureus were transferred to another plate for bacterial identification using MALDI-TOF (bioMérieux®). In simple terms, these colonies were placed on a polymeric matrix plate, followed by laser desorption–ionization mass spectrometry to identify bacteria.
The procedure was as follows: Suspected colonies of S. aureus grown on a blood agar plate are transferred to a target slide in small spots. A drop of α-cyano-4-hydroxycinnamic acid (CHCA) matrix, supplied by bioMérieux, is applied to each spot and left to dry at room temperature. Once the matrix crystallizes, the slide is placed in the ionization chamber of a mass spectrometer. Ultraviolet laser pulses desorb and ionize the sample molecules, which are then accelerated through an electrostatic field and into a vacuum tube. Smaller ions reach the detector faster than larger ones, and their time-of-flight (TOF) is used to calculate m/z values. The resulting mass spectrum is known as a proteomic fingerprint and is compared to a database of spectra from well-characterized microorganisms for identification.
The analysis was performed using the Vitek MS system, with data processing handled by the Myla software program (bioMérieux®, Marcy-l’Étoile, France, version [4.8]), both from bioMérieux. Each spot analysis took approximately one minute. Slides contained three groups of 16 spots each. Quality control was ensured by including Candida glabrata ATCC MYA-2950, Klebsiella aerogenes ATCC 13048, and a negative control on every slide. Additionally, Escherichia coli ATCC 25922 was used as a mandatory control strain for reading the slide.
Antimicrobial susceptibility testing was conducted using the Vitek 2 system (bioMérieux®). The antimicrobials investigated were tigecycline, clindamycin, vancomycin, erythromycin, teicoplanin, gentamicin, levofloxacin, sulfamethoxazole–trimethoprim, linezolid, rifampicin, penicillin, and oxacillin. The results were reported following the guidelines of the Clinical and Laboratory Standards Institute (CLSI) (M100-Ed 29/30) [11].
Antimicrobial susceptibility testing (AST) was carried out using the Vitek System; isolated colonies from the same blood agar plate used for the MALDI-TOF identification were also utilized for the AST. For Gram-positive cocci, the AST-P637 card was employed. A bacterial suspension was prepared in sterile saline and adjusted to a specific density (0.50–0.63 McFarland units) using the DensiCheck system (bioMérieux). The AST card contained predefined concentrations of antimicrobial agents in microdilution wells and was inoculated with the bacterial suspension via a cannula under vacuum in the equipment and then incubated at a controlled temperature (35–37 °C) for up to 18 h.
The Vitek System (bioMérieux®, Marcy-l’Étoile, France, version [4.8]) monitors bacterial growth at each antimicrobial concentration using optical density measurements to determine the minimum inhibitory concentration (MIC) for each drug. The results are interpreted by the accompanying software program based on the guidelines of the Clinical and Laboratory Standards Institute (CLSI), classifying each antimicrobial as susceptible, intermediate, or resistant. Quality control is ensured using strains (e.g., Staphylococcus aureus ATCC 29213). The AST-P637 card tests various antibiotics, such as penicillin, oxacillin, cephalosporins, vancomycin, teicoplanin, levofloxacin, erythromycin, clindamycin, tigecycline, and linezolid.
2.7. Statistical Analysis
The Kolmogorov–Smirnov test was used to assess normality. Data were expressed as mean and standard deviation (SD) or median and interquartile range (IQR). Either Student’s t-test or the Mann–Whitney test was used to compare quantitative variables. Nominal qualitative variables were compared using either the chi-square test or Fisher’s exact test. A logistic regression model was adjusted to determine possible associations between nasal colonization by S. aureus and age, sex, education level, comorbidities, use of catheter/fistula, antibiotic use, duration of dialysis therapy, previous hospitalization, and infection (p < 0.10). All analyses were conducted using SPSS v. 18 (IBM Corp., Armonk, NY, USA). A p-value < 0.05 was considered indicative of statistical significance.
3. Results
In total, 96 patients with CKD undergoing hemodialysis were included in the present study; 35 (35%) were determined to be nasal carriers of S. aureus (Table 1).

Table 1.
Demographic and clinical characteristics of participants.
The mean age was 45 years (standard deviation ± 17.47). Men comprised 49% of the participants. The predominant duration of dialysis was one to five years. Factors associated with colonization were younger age and corticosteroid/immunosuppressant therapies (Table 1). The distribution of other demographic characteristics, comorbidities, and clinical characteristics was similar between non-carriers and carriers. A total of 3 out of the 34 (8.8%) nasal S. aureus carriers were colonized with oxacillin-resistant strains (MRSA). Table 2 displays the characteristics of the patients colonized with MRSA.

Table 2.
Characteristics of patients colonized with MRSA.
Among the 34 nasal S. aureus carriers, more than 50% of the strains of S. aureus were resistant to clindamycin but susceptible to oxacillin (MSSA). The results of the antimicrobial susceptibility testing of S. aureus strains (n = 34) indicated that 55.8% of the strains were resistant to clindamycin, while 44.2% were susceptible; 64.7% of the strains were resistant to erythromycin, while 35.3% were susceptible. None of the strains were resistant to gentamicin, levofloxacin, linezolid, rifampicin, teicoplanin, tigecycline, or vancomycin. Resistance to oxacillin was found in 8.83% of the strains, with 91.17% susceptible. All strains (100%) were resistant to penicillin. Resistance to trimethoprim–sulfamethoxazole (TMP-SMX) was 2.9%, with 97.1% being susceptible. No strains had intermediate resistance profiles for any of the antimicrobials tested (Table 3).

Table 3.
Antimicrobial resistance and susceptibility of S. aureus strains isolated from hemodialysis patients.
4. Discussion
Our results revealed that 3 of the 34 nasal carriers of S. aureus (8.8%) were colonized with oxacillin-resistant strains (MRSA). Additionally, more than half of the S. aureus strains were resistant to clindamycin while being susceptible to oxacillin (MSSA). Regarding risk factors, age and the use of corticosteroids and immunosuppressants were associated with colonization.
Evidence indicating nasal colonization by S. aureus as an independent risk factor for infection by this agent in the population with CKD undergoing hemodialysis is extensively documented in the literature [8,9,10,16,27,28,29]. However, few studies have investigated the risk factors associated with nasal colonization in carriers of S. aureus undergoing hemodialysis for CKD [12].
Over the years, the prevalence of nasal S. aureus carriage has changed, which is attributed to improvements in personal hygiene, shifts in socioeconomic status, and smaller family sizes [12].
We investigated the prevalence of nasal S. aureus carriage in patients with CKD undergoing hemodialysis and identified a rate of 35%. The literature reports Staphylococcus aureus carriage rates ranging from 15% to 55% in healthy adult populations [30,31,32]. This divergence may reflect differences in study populations, screening methods, and microbiological analysis.
In the present study, the prevalence of MRSA strains was 8.8% among patients with CKD undergoing hemodialysis. The rates identified in two meta-analyses were 7.1% [33] and 12.8% [21]. These two studies found higher MRSA colonization rates in patients with CKD undergoing hemodialysis compared to the prevalence of MRSA colonization in the general population reported in a study conducted by the US Centers for Disease Control and Prevention between 2001 and 2004, which ranged from 0.8 to 1.5% [34].
Regarding patients with MRSA colonization (3/34), two shared a potential associated factor: prolonged hemodialysis duration (>120 months). Prolonged treatment may increase patient exposure to S. aureus, contributing to higher colonization rates. The findings of a previous study [34] are consistent with our results. However, additional evidence is required to confirm this association. The third MRSA carrier was a young adult (19 years of age) on dialysis for less time (30 months). However, this patient had a history of previous S. aureus infections in the tunneled hemodialysis access site and had used antibiotics in the previous 12 months to treat the infections. In previous studies, these two factors were reported to be associated with MRSA colonization in patients with CKD undergoing hemodialysis [35,36]. The three MRSA results were promptly conveyed to the infection prevention and control unit of the hospital for appropriate action. The medical team also monitored and managed the affected patients to ensure proper care and adherence to infection control protocols.
The high prevalence of methicillin-resistant S. aureus (MRSA) in patients with chronic kidney disease (CKD) undergoing hemodialysis probably results from frequent healthcare exposure, the use of vascular access devices, and recurrent hospitalizations. Prolonged antibiotic treatments and comorbidities, such as diabetes and hypertension, further increase susceptibility to MRSA colonization and infection. These factors underscore the importance of robust infection control measures and antibiotic stewardship programs [37].
Of note, 55.8% of the S. aureus isolates had a high rate of resistance to clindamycin, which was much higher than that found for oxacillin (8.8%). The clindamycin-resistant isolates were all susceptible to oxacillin (MSSA). Studies by Vicetti et al. [38] and Khamash et al. [39] also found high rates of clindamycin resistance in the S. aureus isolates. Clindamycin resistance results from selective pressure when this antibiotic is used frequently for the empirical management of S. aureus infection and from the dissemination of determinants of clindamycin resistance (erm genes) [35,36].
Regarding risk factors, we identified an association between younger age and nasal colonization of S. aureus in patients with CKD undergoing hemodialysis. A cross-sectional study conducted by Diawara et al. [40] reported a higher colonization rate among individuals aged 18 to 35 years (young adults), followed by those aged 36 to 50 years (adults) and 51 to 83 years (older adults). Conversely, Saxena et al. [41] found that nasal S. aureus carriage was higher among individuals aged 75 to 84 years, followed by those aged 65 to 74 years. This variation suggests that other factors, such as differences in immune conditions, exposure to community or hospital environments, or differences in study methods, may influence the association between age and S. aureus colonization.
We also identified an association between the nasal S. aureus carriage in patients with CKD and the chronic use of corticosteroids or immunosuppressants. This association may be explained by the exogenous use of glucocorticoids, which may elevate endogenous cortisol levels, suppressing the innate immune system and exerting an impact on adaptive immunity and inflammation [42]. One study demonstrated that polymorphisms in the glucocorticoid receptor gene are significantly linked to nasal S. aureus carriage [39].
Our study has several limitations that should be considered. Nasal S. aureus colonization was determined based on a single nasal secretion sample per participant. Thus, it was not possible to determine whether positive results corresponded to intermittent or persistent nasal carriage. The genetic lineage diversity of the strains was not investigated. Screening for S. aureus carrier status was limited to the nasal cavity without investigating other important sites, such as the throat. Additionally, the small sample size may have limited the detection of other factors associated with nasal colonization by S. aureus in this population.
5. Conclusions
As the present study was conducted at a single center with a specific population (patients with chronic kidney disease undergoing hemodialysis), the findings cannot be generalized to all patients with CKD on peritoneal dialysis, those in other stages of CKD, or to other healthcare facilities. In conclusion, the prevalence of nasal colonization by S. aureus, including MRSA strains, was high in this cross-sectional study involving dialysis patients. This colonization may be associated with age and corticosteroid use. Further multicenter studies with larger sample sizes are needed to investigate additional risk factors associated with nasal S. aureus carriage in the population undergoing dialysis.
Author Contributions
Conceptualization: D.T.B., R.A.M.-F., K.P.S.F., S.K.B., F.R., M.J.M. and B.J.P.; formal analysis: D.T.B., L.J.M. and E.S.A.-S.; methodology: K.P.S.F. and A.M.P. resources: D.T.B.; supervision: R.A.M.-F., K.P.S.F., C.F., F.R., M.J.M., B.J.P. and A.C.R.T.H.; writing—original draft: D.T.B., E.S.A.-S., C.F. and A.C.R.T.H.; writing—review and editing: R.A.M.-F., S.K.B., L.J.M., F.R., M.J.M., A.M.P., B.J.P. and C.F. All authors have read and agreed to the published version of the manuscript.
Funding
This study was funded by the National Council for Scientific and Technological Development—CNPq, grant number 316287/2023-7.
Institutional Review Board Statement
This study was conducted in accordance with the ethical precepts stipulated in the Declaration of Helsinki and received approval from the Institutional Review Board of University Nove de Julho (UNINOVE) (protocol code: 3505587 on 13 August 2019) and the Institutional Review Board of the hospital affiliated with the School of Medicine of the University of São Paulo (protocol code: 3645881 on 17 October 2019).
Informed Consent Statement
Informed consent was obtained from all patients involved in this study.
Data Availability Statement
The original contributions presented in this study are included in this article. Further inquiries can be directed to the corresponding author.
Acknowledgments
We thank Alessandra Messina Perini for performing all the microbiological procedures.
Conflicts of Interest
The authors declare no conflicts of interest. The governmental funder had no role in the study design, data collection, analysis, or interpretation; the writing of the manuscript; or in the decision to publish the results.
References
- Danski, T.; Pontes, L.; Amaral, A.; Lind, J. Infecção da Corrente Sanguínea Relacionada a Cateter Venoso Central para Hemodiálise: Revisão Integrativa. Rev. Baiana Enferm 2017, 31, e16342. [Google Scholar] [CrossRef]
- Cais, D.P.; Turrini, R.N.T.; Strabelli, T.M.V. Infecções em pacientes submetidos a procedimento hemodialítico: Revisão sistemática. Rev. Bras. Ter. Intensiv. 2009, 21, 269–275. [Google Scholar] [CrossRef]
- Santos, A.C.; Carvalho, A.; Ribeiro, C.; Sousa, F.; Santana, H.; Moura, H.; Barros, L.; Morelo, L.; Goncalves, M.; Nogueira, M. Sistema Nacional de Vigilância Epidemiológica das Infecções Relacionadas à Assistência à Saúde em Serviços de Diálise. Nota Técnica n 06/2017 GVIMS/GGTES/ANVISA 2017 pp. 4–40. Available online: https://antigo.anvisa.gov.br/resultado-de-busca?p_p_id=101&p_p_lifecycle=0&p_p_state=maximized&p_p_mode=view&p_p_col_id=column-1&p_p_col_count=1&_101_struts_action=%2Fasset_publisher%2Fview_content&_101_assetEntryId=3887577&_101_type=document (accessed on 15 January 2025).
- Eleftheriadis, T.; Liakopoulos, V.; Leivaditis, K.; Antoniadi, G.; Stefanidis, I. Infections in hemodialysis: A concise review—Part 1: Bacteremia and respiratory infections. Hippokratia. 2011, 15, 12–17. [Google Scholar] [PubMed] [PubMed Central]
- Lok, C.E.; Huber, T.S.; Lee, T.; Shenoy, S.; Yevzlin, A.S.; Abreo, K.; Allon, M.; Asif, A.; Astor, B.C.; Glickman, M.H.; et al. KDOQI Clinical Practice Guideline for Vascular Access: 2019 Update. Am. J. Kidney Dis. 2020, 75 (Suppl. S2), S1–S164. [Google Scholar] [CrossRef] [PubMed]
- Vandecasteele, S.J.; Boelaert, J.R.; De Vriese, A.S. Staphylococcus aureus infections in hemodialysis: What a nephrologist should know. Clin. J. Am. Soc. Nephrol. 2009, 4, 1388–1400. [Google Scholar] [CrossRef] [PubMed]
- Jaber, B.L. Bacterial infections in hemodialysis patients: Pathogenesis and prevention. Kidney Int. 2005, 67, 2508–2519. [Google Scholar] [CrossRef] [PubMed]
- Herwaldt, L.A. Reduction of Staphylococcus aureus nasal carriage and infection in dialysis patients. J. Hosp. Infect. 1998, 40 (Suppl. B), S13–S23. [Google Scholar] [CrossRef] [PubMed]
- Grothe, C.; Taminato, M.; Belasco, A.; Sesso, R.; Barbosa, D. Screening and treatment for Staphylococcus aureus in hemodialysis patients: A systematic review and meta-analysis. BMC Nephrol. 2014, 15, 202. [Google Scholar] [CrossRef] [PubMed] [PubMed Central]
- Tacconelli, E.; Carmeli, Y.; Aizer, A.; Ferreira, G.; Foreman, M.G. D’Agata EM. Mupirocin prophylaxis to prevent Staphylococcus aureus infection in patients undergoing dialysis: A meta-analysis. Clin. Infect Dis. 2003, 37, 1629–1638. [Google Scholar] [CrossRef] [PubMed]
- Septimus, E.J.; Schweizer, M.L. Decolonization in Prevention of Health Care-Associated Infections. Clin. Microbiol. Rev. 2016, 29, 201–222. [Google Scholar] [CrossRef] [PubMed] [PubMed Central]
- Wertheim, H.F.; Melles, D.C.; Vos, M.C.; van Leeuwen, W.; van Belkum, A.; Verbrugh, H.A.; Nouwen, J.L. The role of nasal carriage in Staphylococcus aureus infections. Lancet Infect Dis. 2005, 5, 751–762. [Google Scholar] [CrossRef] [PubMed]
- Botelho-Nevers, E.; Gagnaire, J.; Verhoeven, P.O.; Cazorla, C.; Grattard, F.; Pozzetto, B.; Berthelot, P.; Lucht, F. Decolonization of Staphylococcus aureus carriage. Med. Mal. Infect. 2017, 47, 305–310. [Google Scholar] [CrossRef] [PubMed]
- Lederer, S.R.; Riedelsdorf, G.; Schiffl, H. Nasal carriage of meticillin resistant Staphylococcus aureus: The prevalence, patients at risk and the effect of elimination on outcomes among outclinic haemodialysis patients. Eur. J. Med. Res. 2007, 12, 284–288. [Google Scholar] [PubMed]
- Patel, J.B.; Gorwitz, R.J.; Jernigan, J.A. Mupirocin resistance. Clin. Infect. Dis. 2009, 49, 935–941. [Google Scholar] [CrossRef] [PubMed]
- Chow, J.W.; Yu, V.L. Staphylococcus aureus nasal carriage in hemodialysis patients. Its role in infection and approaches to prophylaxis. Arch. Intern. Med. 1989, 149, 1258–1262. [Google Scholar] [CrossRef] [PubMed]
- Sollid, J.U.; Furberg, A.S.; Hanssen, A.M.; Johannessen, M. Staphylococcus aureus: Determinants of human carriage. Infect. Genet. Evol. 2014, 21, 531–541. [Google Scholar] [CrossRef] [PubMed]
- Sakr, A.; Brégeon, F.; Mège, J.L.; Rolain, J.M.; Blin, O. Staphylococcus aureus nasal colonization: An update on mechanisms, epidemiology, risk factors, and subsequent infections. Front. Microbiol. 2018, 9, 2419. [Google Scholar] [CrossRef] [PubMed]
- Verhoeven, P.O.; Gagnaire, J.; Botelho-Nevers, E.; Grattard, F.; Carricajo, A.; Lucht, F.; Pozzetto, B.; Berthelot, P. Detection and clinical relevance of Staphylococcus aureus nasal carriage: An update. Expert Rev. Anti. Infect. Ther. 2014, 12, 75–89. [Google Scholar] [CrossRef] [PubMed]
- Kluytmans, J.; van Belkum, A.; Verbrugh, H. Nasal carriage of Staphylococcus aureus: Epidemiology, underlying mechanisms, and associated risks. Clin. Microbiol. Rev. 1997, 10, 505–520. [Google Scholar] [CrossRef] [PubMed] [PubMed Central]
- Gebreselassie, H.M.; Lo Priore, E.; Marschall, J. Effectiveness of meticillin-resistant Staphylococcus aureus decolonization in long-term haemodialysis patients: A systematic review and meta-analysis. J. Hosp. Infect. 2015, 91, 250–256. [Google Scholar] [CrossRef] [PubMed]
- Souly, K.; Ait el kadi, M.; Lahmadi, K.; Biougnach, H.; Boughaidi, A.; Zouhdi, M.; Benasila, S.; Elyoussefi, Z.; Bouattar, T.; Zbiti, N.; et al. Epidemiology and prevention of Staphylococcus aureus nasal carriage in hemodialyzed patients. Med. Mal. Infect. 2011, 41, 469–474. [Google Scholar] [CrossRef] [PubMed]
- Bezerra, D.T.; La Selva, A.; Cecatto, R.B.; Deana, A.M.; Prates, R.A.; Bussadori, S.K.; Mesquita-Ferrari, R.A.; Motta, L.J.; Fernandes, K.P.S.; Martimbianco, A.L.C.; et al. Antimicrobial Photodynamic Therapy in the Nasal Decolonization of Maintenance Hemodialysis Patients: A Pilot Randomized Trial. Am. J. Kidney Dis. 2023, 81, 528–536.e1. [Google Scholar] [CrossRef] [PubMed]
- Clinical and Laboratory Standards Institute (CLSI). Performance Standards for Antimicrobial Susceptibility Testing. CLSI Supplement M100, 30th ed.; Clinical and Laboratory Standards Institute: Wayne, PA, USA, 2020. [Google Scholar]
- Myla Software. bioMérieux. [Software for Laboratory Workflow and Data Management]. bioMérieux SA. 2023. Available online: https://www.biomerieux.com (accessed on 15 January 2025).
- Weinstein, M.P.; Yagupsky, P.; Greenwood, J.R. Essential Procedures for Clinical Microbiology, 4th ed.; ASM Press: Washington, DC, USA, 2020. [Google Scholar]
- Boelaert, J.R.; Van Landuyt, H.W.; Godard, C.A.; Daneels, R.F.; Schurgers, M.L.; Matthys, E.G.; De Baere, Y.A.; Gheyle, D.W.; Gordts, B.Z.; Herwaldt, L.A. Nasal mupirocin ointment decreases the incidence of Staphylococcus aureus bacteraemias in haemodialysis patients. Nephrol. Dial. Transplant. 1993, 8, 235–239. [Google Scholar] [PubMed]
- Yu, V.L.; Goetz, A.; Wagener, M.; Smith, P.B.; Rihs, J.D.; Hanchett, J.; Zuravleff, J.J. Staphylococcus aureus nasal carriage and infection in patients on hemodialysis. Efficacy of antibiotic prophylaxis. N. Engl. J. Med. 1986, 315, 91–96. [Google Scholar] [CrossRef] [PubMed]
- van Rijen, M.; Bonten, M.; Wenzel, R.; Kluytmans, J. Mupirocin ointment for preventing Staphylococcus aureus infections in nasal carriers. Cochrane Database Syst Rev. 2008, 2008, CD006216. [Google Scholar] [CrossRef] [PubMed] [PubMed Central]
- Anwar, M.S.; Jaffery, G.; Rehman Bhatti, K.U.; Tayyib, M.; Bokhari, S.R. Staphylococcus aureus and MRSA nasal carriage in general population. J. Coll. Physicians Surg. Pak. 2004, 14, 661–664. [Google Scholar] [PubMed]
- Hu, L.; Umeda, A.; Kondo, S.; Amako, K. Typing of Staphylococcus aureus colonising human nasal carriers by pulsed-field gel electrophoresis. J. Med. Microbiol. 1995, 42, 127–132. [Google Scholar] [CrossRef] [PubMed]
- Nouwen, J. Determinants, Risks & Dynamics of Staphylococcus Aureus Nasal Carriage. 2004. Available online: http://hdl.handle.net/1765/51592 (accessed on 15 January 2025).
- Zacharioudakis, I.M.; Zervou, F.N.; Ziakas, P.D.; Mylonakis, E. Meta-analysis of methicillin-resistant Staphylococcus aureus colonization and risk of infection in dialysis patients. J. Am. Soc. Nephrol. 2014, 25, 2131–2141. [Google Scholar] [CrossRef] [PubMed] [PubMed Central]
- Gorwitz, R.J.; Kruszon-Moran, D.; McAllister, S.K.; McQuillan, G.; McDougal, L.K.; Fosheim, G.E.; Jensen, B.J.; Killgore, G.; Tenover, F.C.; Kuehnert, M.J. Changes in the prevalence of nasal colonization with Staphylococcus aureus in the United States, 2001-2004. J. Infect. Dis. 2008, 197, 1226–1234. [Google Scholar] [CrossRef] [PubMed]
- Celik, G.; Gülcan, A.; Dikici, N.; Gülcan, E. Prevalence of nasal Staphylococcus aureus carriage in the patients undergoing hemodialysis and evaluation of risk factors and laboratory parameters. Ren. Fail. 2011, 33, 494–498. [Google Scholar] [CrossRef] [PubMed]
- Lu, P.L.; Tsai, J.C.; Chiu, Y.W.; Chang, F.Y.; Chen, Y.W.; Hsiao, C.F.; Siu, L.K. Methicillin-resistant Staphylococcus aureus carriage, infection and transmission in dialysis patients, healthcare workers and their family members. Nephrol. Dial. Transplant. 2008, 23, 1659–1665. [Google Scholar] [CrossRef] [PubMed]
- Zeller, J.L.; Golub, R.M. JAMA patient page. MRSA infections. JAMA 2011, 306, 1818. [Google Scholar] [CrossRef] [PubMed][Green Version]
- Vicetti Miguel, C.P.; Mejias, A.; Leber, A.; Sanchez, P.J. A decade of antimicrobial resistance in Staphylococcus aureus: A single center experience. PLoS ONE 2019, 14, e0212029. [Google Scholar] [CrossRef] [PubMed]
- Khamash, D.F.; Voskertchian, A.; Tamma, P.D.; Akinboyo, I.C.; Carroll, K.C.; Milstone, A.M. Increasing Clindamycin and Trimethoprim-Sulfamethoxazole Resistance in Pediatric Staphylococcus aureus Infections. J. Pediatr. Infect. Dis. Soc. 2019, 8, 351–353. [Google Scholar] [CrossRef] [PubMed]
- Diawara, I.; Bekhti, K.; Elhabchi, D.; Saile, R.; Elmdaghri, N.; Timinouni, M.; Elazhari, M. Staphylococcus aureus nasal carriage in hemodialysis centers of Fez, Morocco. Iran. J. Microbiol. 2014, 6, 175–183. [Google Scholar] [PubMed] [PubMed Central]
- Saxena, A.K.; Panhotra, B.R.; Chopra, R. Advancing age and the risk of nasal carriage of Staphylococcus aureus among patients on long-term hospital-based hemodialysis. Ann. Saudi Med. 2004, 24, 337–342. [Google Scholar] [CrossRef] [PubMed] [PubMed Central]
- Nouwen, J.L.; van Belkum, A.; Verbrugh, H.A. Determinants of Staphylococcus aureus nasal carriage. Neth. J. Med. 2001, 59, 126–133. [Google Scholar] [CrossRef] [PubMed][Green Version]
Disclaimer/Publisher’s Note: The statements, opinions and data contained in all publications are solely those of the individual author(s) and contributor(s) and not of MDPI and/or the editor(s). MDPI and/or the editor(s) disclaim responsibility for any injury to people or property resulting from any ideas, methods, instructions or products referred to in the content. |
© 2025 by the authors. Licensee MDPI, Basel, Switzerland. This article is an open access article distributed under the terms and conditions of the Creative Commons Attribution (CC BY) license (https://creativecommons.org/licenses/by/4.0/).